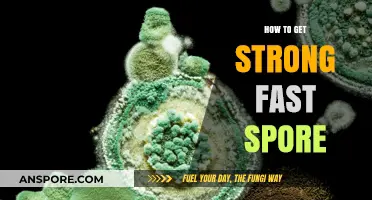
Rapid Spore Strength: Proven Techniques for Quick and Powerful Growth

Obtaining a spore print from store-bought portobello mushrooms is a fascinating and straightforward process that allows you to observe the mushroom's reproductive structures up close. Portobellos, being mature cremini mushrooms, release spores from the gills on their undersides, which can be captured on a surface to create a spore print. This method is not only a great way to learn about fungal biology but also serves as a stepping stone for those interested in mushroom cultivation. By carefully placing the mushroom cap on a piece of paper or glass, you can collect the spores that naturally fall, providing a visual representation of the mushroom's unique spore color and pattern. Whether for educational purposes, artistic endeavors, or the first step in growing your own mushrooms, creating a spore print from store-bought portobellos is an accessible and rewarding activity.
| Characteristics | Values |
|---|---|
| Mushroom Type | Portobello (Agaricus bisporus) |
| Spore Print Color | Dark brown to black |
| Required Materials | Portobello mushroom, glass or jar, white paper/foil, knife, gloves |
| Preparation Time | 10-15 minutes (plus waiting time for spore release) |
| Steps | 1. Cut the mushroom stem close to the cap. 2. Place the cap gill-side down on paper/foil. 3. Cover with a glass/jar to create humidity. 4. Wait 2-6 hours for spores to drop. 5. Lift the cap carefully to reveal the spore print. |
| Storage | Store spore print in a sealed container or between wax paper in a cool, dry place. |
| Shelf Life of Spores | 6-12 months if stored properly |
| Notes | Store-bought mushrooms may be less viable for spore prints due to age or treatment. Always wear gloves to avoid contamination. |
What You'll Learn
- Prepare sterile workspace - Clean surface, gloves, alcohol wipes, and cover nearby items to prevent contamination
- Select healthy mushroom - Choose a fresh, unbruised portobello with open gills for clear spore release
- Place on paper/glass - Position mushroom gill-side down on white paper or glass for spore collection
- Cover with container - Use a bowl or jar to cover the mushroom, ensuring spores fall onto surface
- Wait and store - Leave for 6+ hours, then carefully remove mushroom; let print dry before storing

Prepare sterile workspace - Clean surface, gloves, alcohol wipes, and cover nearby items to prevent contamination
Creating a sterile workspace is the cornerstone of obtaining a viable portobello spore print, as contamination can render the entire process futile. Begin by selecting a clean, flat surface away from high-traffic areas to minimize airborne particles. Use a 70% isopropyl alcohol solution to thoroughly wipe down the surface, ensuring all visible dirt and potential microbial colonies are eradicated. Allow the area to air-dry for at least 2 minutes to let the alcohol evaporate completely, leaving behind a disinfected zone. This step is not merely precautionary—it’s essential, as even a single contaminant can outcompete the spores, ruining your efforts.
Gloves are your first line of defense against introducing skin oils, bacteria, or fungi into the process. Opt for nitrile or latex gloves, ensuring they fit snugly to maintain dexterity. Before handling any materials, sanitize the gloves by wiping them with an alcohol wipe, paying special attention to the fingertips and palms. Change gloves if they become torn or contaminated during the process, as even a small breach can compromise sterility. Remember, gloves protect both the experiment and the handler, especially if working with store-bought mushrooms that may harbor unknown substances.
Alcohol wipes are your most versatile tool in this endeavor, serving as both a disinfectant and a quick-fix for potential contamination points. Use them to clean scissors, tweezers, or any other tools before they come into contact with the mushroom or workspace. For surfaces that cannot be wiped, such as porous materials or electronic devices, cover them with sterile drapes or plastic wrap to create a barrier. This step is often overlooked but critical, as nearby items like keyboards, phones, or even clothing can harbor spores or bacteria that could drift into your workspace.
Covering nearby items is a practical yet often underestimated measure in maintaining a sterile environment. Use disposable plastic sheeting or clean cloth to shield objects within a 2-foot radius of your workspace. Ensure the covering is secure, with no gaps that could allow dust or particles to infiltrate. If working in a confined space, consider using a portable laminar flow hood or a DIY version made from a cardboard box and a HEPA filter to create a localized clean air zone. While this may seem excessive for a home setup, it significantly reduces the risk of airborne contamination, especially in environments with poor ventilation.
Finally, adopt a mindset of vigilance throughout the process. Treat your workspace as a temporary cleanroom, minimizing movement in and out of the area. If possible, work during a time when the environment is least disturbed, such as early morning or late evening. Keep a spray bottle of 70% isopropyl alcohol nearby for immediate spot-cleaning if accidental contamination occurs. By combining these measures—cleaning, gloving, wiping, and covering—you create a sterile sanctuary where portobello spores can be safely captured, ensuring the success of your spore print endeavor.
Where to Legally Purchase Psilocybin Spores: A Comprehensive Guide
You may want to see also

Select healthy mushroom - Choose a fresh, unbruised portobello with open gills for clear spore release
Selecting a healthy portobello mushroom is the cornerstone of obtaining a clear and viable spore print. The mushroom’s condition directly impacts the quality of the spores released, so prioritize freshness and structural integrity. Look for a specimen with firm, unbruised flesh and a cap that shows no signs of decay, such as sliminess or discoloration. A healthy portobello will feel heavy for its size, indicating proper hydration and vitality. Avoid mushrooms with damaged stems or caps, as these may harbor contaminants or fail to release spores effectively.
The gills of the portobello are the spore-producing structures, so their condition is critical. Choose a mushroom with gills that are fully exposed and not tightly packed. Open gills ensure unobstructed spore release, while closed or immature gills may yield incomplete or unclear prints. Gently examine the underside of the cap to confirm the gills are brown and well-defined, as this indicates the mushroom is at the optimal stage for spore collection. If the gills appear pale or underdeveloped, the mushroom is likely too young and will not produce a satisfactory print.
A persuasive argument for selecting the healthiest portobello lies in the efficiency of the spore collection process. A fresh, unbruised mushroom with open gills minimizes the risk of contamination and maximizes spore yield. Contaminated or damaged mushrooms may introduce bacteria or mold, compromising the viability of the spores. By investing time in choosing the right specimen, you ensure a higher success rate in both the spore print and subsequent cultivation efforts. Think of it as laying a strong foundation for your mycological endeavors.
Practically, here’s how to apply this knowledge in a store setting. Inspect the portobello caps for symmetry and uniformity, as these traits often correlate with health. Press gently on the cap’s surface; it should bounce back slightly, indicating freshness. If the mushroom feels spongy or leaves an indentation, it’s likely past its prime. Additionally, check the packaging date if available, and opt for mushrooms displayed in well-ventilated areas to avoid those exposed to excess moisture. These simple steps can significantly improve your chances of a successful spore print.
Can Spores Trigger Nausea? Exploring the Surprising Connection
You may want to see also

Place on paper/glass - Position mushroom gill-side down on white paper or glass for spore collection
The delicate gills of a Portobello mushroom are nature's own spore factories, and capturing their print is a fascinating glimpse into the hidden world of fungal reproduction. To begin, select a mature specimen with gills that are fully exposed and dark brown in color, indicating peak spore production. Gently hold the mushroom cap by its stem, taking care not to touch the gills, as oils from your skin can interfere with spore release.
A clean, dry surface is crucial for a successful spore print. White paper or a glass slide provides optimal contrast, allowing you to clearly see the spore pattern and color. For a more permanent record, consider using a glass microscope slide, which can be labeled, stored, and examined under magnification for detailed analysis.
Positioning the mushroom gill-side down is the key to unlocking its spore secrets. Imagine the gills as tiny ink pads, each one loaded with microscopic spores waiting to be transferred. By placing the mushroom cap directly onto the paper or glass, you create a direct pathway for the spores to fall. Gravity does the rest, as the spores gently rain down, forming a pattern that mirrors the arrangement of the gills. This method is not only simple but also highly effective, yielding a clear and detailed spore print within a few hours.
While the process is straightforward, a few precautions ensure success. Avoid using porous surfaces like cardboard or rough paper, as spores can become trapped and difficult to see. Similarly, ensure the environment is calm and free from drafts, as air movement can disrupt the spore fall. For best results, place the mushroom in a covered container, such as a glass jar or plastic bag, to create a humid microclimate that encourages spore release. Patience is key; allow the mushroom to remain undisturbed for 6–12 hours, or overnight, for a complete and vibrant spore print.
The resulting spore print is more than just a visual curiosity—it’s a valuable tool for identification, cultivation, and scientific study. The color and pattern of the spores can help confirm the mushroom species, while the print itself can be used to inoculate substrate for growing new mushrooms. For enthusiasts and mycologists alike, this simple technique opens doors to deeper exploration of the fungal kingdom, all starting with the careful placement of a Portobello mushroom on paper or glass.
Mycotoxin Spores: Are They Smaller Than 3 Microns?
You may want to see also

Cover with container - Use a bowl or jar to cover the mushroom, ensuring spores fall onto surface
A spore print is a simple yet fascinating way to capture the reproductive essence of a mushroom, and covering the mushroom with a container is a crucial step in this process. By using a bowl or jar, you create a controlled environment that ensures the spores fall onto a designated surface, rather than being dispersed into the air or lost to the surroundings. This method is particularly effective for store-bought portobello mushrooms, which are mature and likely to release a substantial amount of spores.
Steps to Cover with Container:
- Select a Suitable Container: Choose a glass bowl or jar with a wide opening, ensuring it’s clean and dry. The container should be large enough to fully cover the mushroom cap without touching it, as contact can disrupt spore release. A standard mason jar or a salad bowl works well for most portobello mushrooms.
- Prepare the Surface: Place a piece of aluminum foil, white paper, or glass slide inside the container, directly under where the mushroom will sit. These surfaces allow for easy visualization and collection of the spores. For best results, use a contrasting color (e.g., white paper for dark spores, black paper for light spores).
- Position the Mushroom: Gently place the portobello mushroom cap-side down on the prepared surface, ensuring the gills are fully exposed. The stem should rest on the container’s base, stabilizing the mushroom without obstructing spore release.
- Cover and Secure: Carefully place the container over the mushroom, creating a sealed environment. If using a jar, you can secure it with a piece of tape or elastic band to prevent accidental movement. Leave the setup undisturbed for 6–12 hours, ideally overnight, to allow spores to drop.
Cautions and Tips:
Avoid using plastic containers, as static electricity can interfere with spore collection. If the mushroom is particularly moist, place a small spacer (like a toothpick) between the cap and the surface to prevent sticking. For multiple mushrooms, use separate containers to avoid cross-contamination of spore prints.
Covering a portobello mushroom with a container is a straightforward yet essential technique for obtaining a clean, detailed spore print. This method not only maximizes spore collection but also provides a clear visual representation of the mushroom’s reproductive characteristics. Whether for scientific study, artistic purposes, or personal curiosity, this approach ensures reliable results with minimal effort.
Are Spores Metabolically Active? Unraveling the Dormant Life Cycle Mystery
You may want to see also

Wait and store - Leave for 6+ hours, then carefully remove mushroom; let print dry before storing
Time is a critical factor in capturing a pristine Portobello spore print. Rushing the process risks smudging or incomplete prints, rendering them useless for identification or cultivation. The "wait and store" method, involving a minimum six-hour incubation period, ensures optimal spore release and preservation. This technique prioritizes patience over haste, allowing the mushroom's natural processes to unfold undisturbed.
Imagine a Portobello cap, its gills ripe with spores, placed gently on a surface. Over six hours, these microscopic particles, propelled by gravity and air currents, settle in a pattern mirroring the gill arrangement. This delicate process demands a stable environment, free from vibrations or drafts that could disrupt the spore deposition. A glass or ceramic surface, cleaned with isopropyl alcohol and allowed to dry, provides an ideal, sterile canvas for this natural artwork.
Opting for this method requires planning and foresight. Six hours is a minimum; leaving the mushroom overnight (12-14 hours) often yields more complete prints, especially for mature specimens. Once the waiting period concludes, the mushroom is carefully lifted, ensuring no smudging occurs. The spore print, now exposed, should be allowed to air dry completely before storage. This drying process, typically taking several hours in a well-ventilated area, prevents mold growth and ensures the print's longevity.
This method, while seemingly simple, demands attention to detail. A slight misstep – a premature lift, a dusty surface, or inadequate drying – can compromise the print's integrity. However, when executed correctly, the "wait and store" technique yields a valuable record of the Portobello's genetic blueprint, a testament to the beauty and complexity of fungal reproduction.
Do All Fungi Develop Exclusively from Spores? Unveiling the Truth
You may want to see also
Frequently asked questions
A portabella spore print is a collection of spores released by the mushroom's gills onto a surface. It’s used for identification, art, or cultivation. Getting one from a store-bought mushroom allows you to study its spores or grow your own mushrooms at home.
A: Gently clean the mushroom cap with a soft brush or damp cloth to remove dirt. Ensure the gills are intact and undamaged. Place the cap gill-side down on a piece of paper or glass, and cover it with a bowl to create a humid environment.
It typically takes 6–24 hours for the spores to drop onto the surface. Leave the setup undisturbed in a cool, dry place and check periodically until the spores are visible as a fine, colored dust.
Yes, you can use the spore print for cultivation. However, store-bought mushrooms may not always produce viable spores or consistent results. For better success, consider using spores from a trusted supplier or a fresh, locally sourced mushroom.